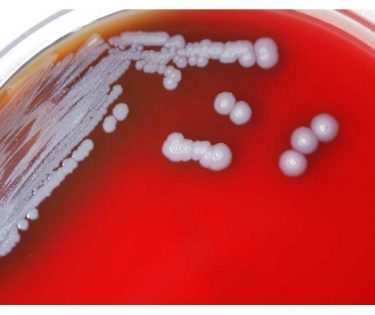

Stiri
Serviciul ucrainean de securitate de stat afirmă că investighează 752 de cazuri de trădare și colaborare
Conform datelor transmise de autoritățile ucrainene, cel mai mare număr de cazuri este investigat în regiunile Lugansk, Donețk, Zaporizhzhia și Herson. În același timp, Ucraina a deschis, 1.451 de proceduri penale care investighează infracțiuni împotriva copiilor. „O anchetă este în curs de desfășurare cu privire …
vezi stireaCalifornia a declarat luni stare de urgenţă ca urmare a răspândirii virusului variolei maimuţei
California a declarat luni stare de urgenţă ca urmare a răspândirii virusului variolei maimuţei, pentru a „consolida eforturile de vaccinare ale statului, informează marţi DPA/TCA. „California acţionează de urgenţă la toate nivelurile de guvernare pentru a încetini răspândirea variolei maimuţei, prin mobilizarea testelor noastre robuste, …
vezi stireaJoe Biden a confirmat uciderea liderului Al-Qaida, Ayman Al-Zawahiri
Preşedintele SUA, Joseph Biden, a confirmat eliminarea într-o operaţiune efectuată în Afganistan a liderului reţelei teroriste Al-Qaida, Ayman Al-Zawahiri, pe care l-a acuzat de implicarea într-o serie de atacuri contra cetăţenilor americani, inclusiv în atentatele din 11 septembrie 2001. Ayman Al-Zawahiri a comis „o serie …
vezi stireaInformNapalm anunță că o colonie de prizonieri ucraineni a fost ucisă prin folosirea armelor termobarice
Distrugerea coloniei din Olenivka, acolo unde au decedat 53 de prizonieri de război ucraineni, demonstrează că ruşii ar fi putut folosi arme termobarice pentru a arde prizonierii în somn deoarece nu există urme ale unei explozii. Deși propaganda rusă susține că prizonierii au fost uciși …
vezi stireaPrima navă încărcată cu cereale ucrainene a plecat din portul Odesa
Prima navă încărcată cu cereale ucrainene a plecat luni din portul Odesa, conform acordului semnat la Istanbul cu Rusia, a anunţat Ministerul turc al Apărării. Bombardamentele rusești au continuat în Nikolaev și Harkov. Cel puțin doi oameni au murit. Între timp, rușii își repoziționează trupele, …
vezi stireaIvana Trump, prima soție a fostului președinte al SUA Donald Trump, a fost îngropată pe terenul din golf din New Jeresey
Ivana Trump, prima soție a fostului președinte al SUA Donald Trump, a fost înmormântată lângă prima gaură a clubului național de golf Trump din New Jersey. Potrivit codului fiscal din New Jersey, terenul care este dedicat unui cimitir este scutit de toate taxele, ratele și evaluările. …
vezi stireaMinistrul german de finanţe, Christian Lindner, a cerut încetarea producţiei de energie pe bază de gaz natural
Ministrul german de finanţe, Christian Lindner, a cerut încetarea producţiei de energie pe bază de gaz natural, în contextul temerilor că Germania ar putea intra într-o criză a gazelor. „Trebuie să luăm măsuri pentru a evita o criză energetică, suprapusă peste criza gazelor. Gazul nu …
vezi stireaParchetul din Barcelona a anunţat vineri că va cere o pedeapsă de peste opt ani de închisoare pentru Shakira
În actul acuzării, consultat de jurnaliştii de la AFP, Parchetul din Barcelona a precizat că va solicita şi o amendă de aproape 24 de milioane de euro pentru cântăreaţa pop, acuzată că s-a sustras de la plata unei sume de 14,5 milioane de euro către …
vezi stireaViktor Orban anunţă că va semna un acord cu Rusia privind livrări suplimentare de gaze
Ungaria se aşteaptă să semneze un acord cu Rusia privind livrări suplimentare de gaze de 700 de milioane de metri cubi până la sfârşitul verii, a declarat vineri premierul Viktor Orban la radioul de stat. Cele două ţări au purtat discuţii pentru livrări suplimentare pe …
vezi stireaO nouă bacterie care provoacă o boală rară și gravă a fost descoperită în SUA
Bacteria care cauzează o boală rară și gravă numită melioidoză a fost detectată în probe de apă și sol din Mississippi. „Încă nu sunt informații certe despre perioada în care bacteria a fost în mediu înainte de 2020 sau cât de răspândită este bacteria în …
vezi stirea